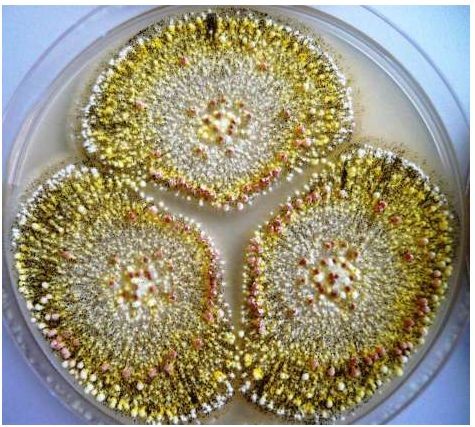

普洱茶里全是致癌物,一口都不能喝吗?辟谣:不存在患癌的问题
普洱茶里全是致癌物,一口都不能喝吗?辟谣:不存在患癌的问题
“立刻停下!普洱茶里全都是致癌物,长期喝会致癌!”
对于经常喝茶养生的人,这好像是魔咒一般,再也不敢喝普洱茶了,可这其中的原因到底是什么呢?据说是普洱茶中有黄曲霉毒素,人接触后会有致癌的危险。
黄曲霉毒素致癌?
这点是毋庸置疑的,黄曲霉毒素主要是黄曲霉以及多种霉株,进而延伸出的毒素,光是延伸物就能达到20多种,尤其需要大家关注的是黄曲霉毒素B1,毒性最大,致癌性最强。
据资料显示,在早期1993年时,黄曲霉毒素就已被世界卫生组织国家癌症研究机构,列为1类致癌物。那这么说,喝普洱茶会患癌吗?

等等,你可知黄曲霉毒素和普洱茶之间的关系吗?
传言并非真相,普洱茶出生于云南的西双版纳,最早在周朝时就有记载,后来因为制作方式,包括普洱紧茶、普洱绿茶、偶尔红茶、普洱青茶、普洱黄茶、普洱黑茶、普洱白茶。
由于它属于发酵型茶,有人认为它在发酵过程中容易滋生黄曲霉毒素。经过相关的实验证明,普洱茶在发酵后并不会产生黄曲霉毒素,后期食品安全主要看保存问题。

特别是喜欢喝普洱茶的人,储存时湿度较大,环境污染大,普洱茶中可能含有细菌病毒,但毕竟有那么一句话“抛开剂量谈毒性都是胡扯”。所以,对于这样的普洱茶,为了安全起见,需要大家注意两方面,是可以放心吃的。
一方面是普洱茶保存,有的家庭普洱茶保存时间很长,甚至能达到五年以上。关于它的存放,针对不同品质的生熟普洱茶,两种茶要分开放置,可用牛皮纸、棉纸包裹,也可放在容器内,避免大量的湿气感染茶叶品质。

同时注意普洱茶的保质期,一旦超出时间范围,最好不喝为宜。
另一方面,安全与健康起见,买任何茶叶都需要大家去正规地方,超市或者是茶叶店购买,以确保茶叶的品质。与此同时,相比于带包装的茶,最好不要买散装的茶。

选购安全健康的普洱茶,每天适量喝具有养胃护胃、消炎杀菌、延缓衰老、生津止渴、润肠通便等好处。除了普洱茶以外,大家还可以选择红茶、绿茶、白茶、黑茶......大家可以根据自身体质选择最适合自己的茶水。
尤其对于水无感的人,茶水可以是很好的供水选择,以保证每日水资源的供应。
-
- 金蟾——金玉满屏,招财纳福的吉祥物
-
2025-12-24 17:09:48
-
- 判了!黄奕前夫黄毅清,数罪并罚被判16年,不可一世终将付出代
-
2025-12-23 19:05:04
-
- 百年品牌嘉陵,全国南北方统一战略,天津电动车展将有大动作
-
2025-12-22 23:45:37
-
- 人的生存是共性与个性的结合体
-
2025-12-21 17:48:08
-
- 别再争论西户和东户了!入住12年,我搬到了中间户
-
2025-12-21 00:11:34
-
- 水果店利润有多大?3个引流获客妙招回头客稳定
-
2025-12-17 18:46:34
-
- 中国神话动物在哪里04?!人面鱼身的赤鱬是什么?
-
2025-12-17 00:22:27
-
- 正高级教师和特级教师哪个含金量厉害
-
2025-12-17 00:20:13
-
- 投资141亿的北京工业大学新校区,来了!
-
2025-12-17 00:17:59
-
- 唐嫣安检不脱外套怎么回事?唐嫣安检为何不脱外套引网友质疑耍大牌
-
2025-12-17 00:15:44
-
- 你知道“孟婆汤”是如何熬制的吗,你喝的又是哪一味呢
-
2025-12-17 00:13:30
-
- 复兴门:没有城门的长安街西大门
-
2025-12-17 00:11:16
-
- 39岁佟丽娅发视频为儿子庆生,母子俩举红色气球在海边奔跑嬉戏:七岁生日快乐
-
2025-12-17 00:09:01
-
- 悬疑惊悚片《凤凰城遗忘录》改编自真实的“UFO事件”
-
2025-12-17 00:06:47
-
- 微鲤看看听歌赚钱在哪里怎么弄 微鲤看看听歌赚钱是真的吗
-
2025-12-17 00:04:32
-
- 说一个人好a是什么意思 形容说男生太a是什么梗、由来出处
-
2025-12-17 00:02:18
-
- 我们常听到的那句“雅美蝶”到底是什么意思
-
2025-12-15 15:38:31
-
- 她被赞是最美乡村女子,私下其实非常洋气
-
2025-12-15 15:36:17
-
- 收藏!2022警察专属手机壁纸
-
2025-12-15 15:34:03
-
- 真正聪明的孩子,晚开窍的可能性极低
-
2025-12-15 15:31:48



骨灰盒下葬红布要不要拿掉(骨灰盒下葬需要盖布吗)
4所公安部直属警校,中等生就能上,毕业包分配,待遇堪比公务员
关于张海迪的丈夫的信息
王千源老婆是谁 圈外老婆于倩照片资料及女儿遭扒
杰森斯坦森揭开与郭达的身世之谜,两人终于承认
广西桂林成为全国第五个直辖市,可行性有多大,会带来哪些影响?
我与隔壁漂亮的女邻居,一个美好的邂逅
大师王林风流往事,为几十名女星“开光”,李冰冰周迅都是座上宾
乔家大院翠儿大结局
海角论坛网页版怎么进入